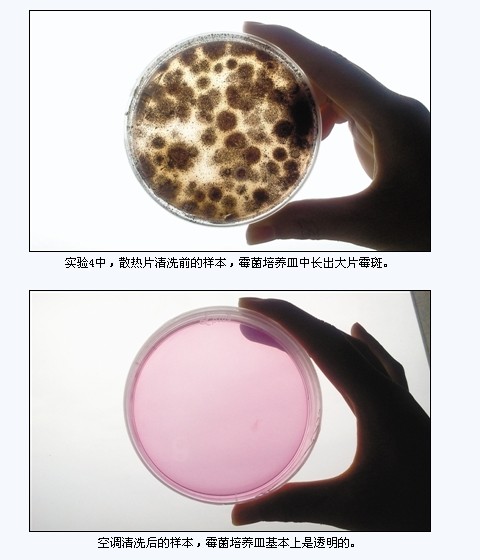

近9成空调散热片细菌超标:3天可吹霉白米饭
(来源:新京报)
新京报记者(采写 魏铭言 摄影 王嘉宁)随中华预防医学会消毒分会专家和家安实验室工作人员,对市民家空调进行取样实验
产品推荐
-
美的(Midea) 1.5P变频空调 KFR-35GW/BP2DN1Y-J(2) (限北京)珠光白
新七天价: 4786.00
-
美的(Midea) 大1P壁挂式空调 KFR-26GW/BP2DN1Y-F(3) (限北京)白色
新七天价: 3410.00
-
美的(Midea) 1.5P壁挂式空调 KFR-35GW/BP2DN1Y-JM5(3)(限北京)白色
新七天价: 3099.00
-
科龙 (Kelon) KFR-26GW/UG-N3 大1P 节能明星系列壁挂式 家用冷暖空调 银灰色 (限北京)
新七天价: 1808.00







